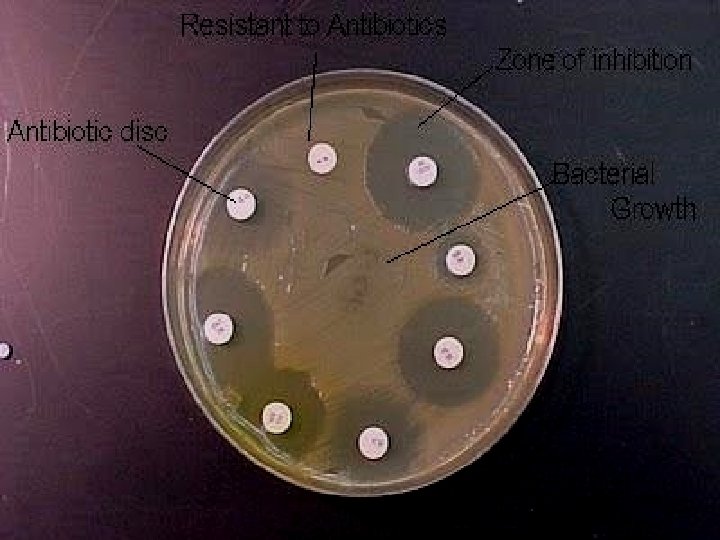

Antibiotic Susceptibility Testing Presented By Dr QuratUlAin Antibiotic

Antibiotic Susceptibility Testing Presented By Dr. Qurat-Ul-Ain

Antibiotic Susceptibility: � Antibiotic sensitivity test (AST) is a laboratory method for determining the susceptibility of organisms to therapy with antibiotics. � Antibiotic susceptibility testing is usually carried out to determine which antibiotic will be most successful in treating a bacterial infection in vivo. Methods Used: 1. Kirby-Bauer Method (Disc diffusion method). 2. Dilution method. 3. Epsilometer test or simply E-Test.

Preparation of the inoculum: The routinely used method is the turbidity standard (0. 5 Mcfarland). Emulsify 2 -3 colonies in sterile saline matching the turbidity to that standard.

1 - Kirby-Bauer Method (Disc Diffusion Test): � Commonly used method for determining the antibiotic susceptibility of a bacteria. � The test can be done by using : 1. Pure cultures of the organism isolated from the pathologic specimen. 2. Directly on the pathologic specimen (pus, urine, sputum, ect. ) prior to isolation of each organism. � Although the former method may preferred, the latter has certain advantages such as: 1. More rapid results. 2. The results will be more relevant to the case , since the inoculums represent more correctly the condition of the patient.

Materials: 1. Muller Hinton Agar. 2. Antibiotic Disks. 3. Turbidity Standard. 4. Swabs.

� Procedure: 1. Mostly Muller Hinton agar is used in this antibiotic susceptibility test. 2. Take 24 -48 hours old broth (Liquid) culture of bacteria to be tested. 3. Place a sterile cotton swab in the bacterial suspension and remove the excess fluid by pressing and rotating the cotton against the inside of the tube above the fluid level. 4. The swab is streaked in three directions over the surface of the Mueller-Hinton agar to obtain uniform growth. A final sweep is made around the rim of the agar.

5. Allow the plates to dry for five minutes. 6. Using sterile forceps or a suitable disc dispenser, place paper disks impregnated with a fixed concentration of an antibiotic, on the surface agar plates at equal distance. 7. Incubate the plates at 37 o. C for 24 hours. 8. Following overnight incubation, measure the diameter of the zone of inhibition in millimeter (mm) around each disk.

1 - Taking broth culture with a swab 2 - Streaking swab on agar surface

ØThe antibiotic discs may be placed on the inoculated plates using: 1 - Placing the disc with a sterile Forcep on agar surface. 2 - Or using an antibiotic dispenser.

Measuring diameter of zone of inhibition by using a ruler in mm

ØUsing a standard table of antibiotic susceptibilities, determine if the strain is resistant (No zone), intermediate (Small zone), or susceptible (Larger zone) to the antibiotics tested.


2 - Dilution method: � Used to determine the minimal concentration of the antibiotic to inhibit or kill micro organisms. � Achieved by: 1. Tube dilution methods. 2. Agar dilution method. � Minimum inhibitory concentration (MIC): The lowest � Minimum bactericidal concentration (MBC): Lowest concentration of antibiotic that inhibit growth of bacteria. concentration of antibiotic that kills bacteria isolated from patient.

1. Tube dilution methods: � In this method we use sterile Muller Hinton broth. � We make 2 -folds dilution of antibiotics in the broth i. e. 2µg/ml, 4µg/ml, 8µg/ml, 16µg/ml and so on. � Then we add broth culture (0. 1 ml) of test organism to the prepared dilutions. Two types of dilution methods can be used: a) Micro-dilution method: � It is performed in 96 well microtiter plate. � We use about 0. 1 ml total broth volume.



b) Macro-dilution method � We use test tubes for this test. � We use about 1 ml total broth volume in which we make 2 -folds dilution of antibiotic. Incubation: � In both dilution methods, after adding test organism we incubate the tubes at 37 o. C for 24 hours. � Then we determine minimum inhibitory concentration (MIC) of antibiotic in µg/ml. � Minimum concentration of antibiotic that inhibits the growth of bacteria i. e. when we see a clear broth.



MBC

The minimal bactericidal concentration (MBC) can be determined by sub culturing all tubes showing no visible turbidity. The tube with the highest dilution that fails to yield growth on the subculture plate contains the MBC of antibiotic for the test strain.

2. Agar dilution method: � Serial dilution of antibiotics are prepared in agar and poured into plates.

3 - Epsilometer test or E-test: It is a quantitative assay for determining the Minimum Inhibitory Concentration (MIC) of antimicrobial agents against microorganisms and for detecting the resistance mechanisms. MIC Test Strip are paper strips with special features that are impregnated with a predefined concentration gradient of antibiotic. On one side of the strip is indicated a MIC scale in μg/ml and a code that identify the antimicrobial agent.

� The exponential gradient of antimicrobial agent is immediately transferred to the agar matrix. � After 18 hours incubation or longer, a symmetrical inhibition ellipse centered along the strip is formed. � The MIC is read directly from the scale in terms of μg/ml at the point where the edge of the inhibition ellipse intersects the MIC Test Strip. � Advantages: 1. Simple. 2. Active. 3. Reliable.

Procedure: 1. Take 24 -48 hours old broth (Liquid) culture of bacteria to be tested. 2. Place a sterile cotton swab in the bacterial suspension and remove the excess fluid by pressing and rotating the cotton against the inside of the tube above the fluid level. 3. The swab is streaked in three directions over the surface of the Mueller-Hinton agar to obtain uniform growth. A final sweep is made around the rim of the agar. 4. Allow the plates to dry for five minutes.

5. With the help of sterile forcep apply E-test strips at equal distance on inoculated Muller Hilton agar plate. 6. Incubate the plates at 37 o. C for 24 hours. 7. Following overnight incubation, an inhibition ellipse is produced. 8. Edge of the ellipse corresponding to the antibiotic concentration on the scale indicates the MIC.



Ideal antibiotic therapy is based on determination of the etiological agent and its relevant antibiotic sensitivity. Empiric treatment is often started before laboratory microbiological reports are available when treatment should not be delayed due to the seriousness of the disease.
- Slides: 30